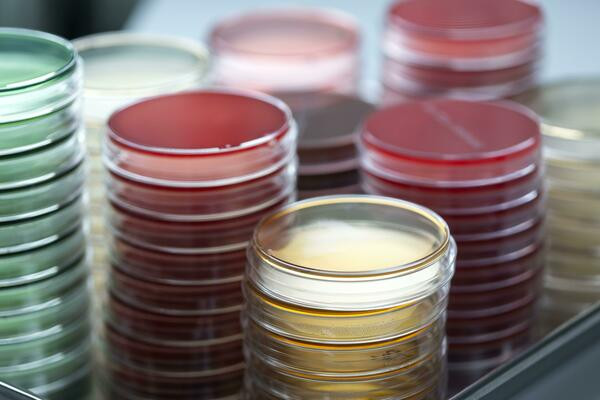
قیمت روز محیط کشت آماده ای ام بی پلیت ۸ دوخانه

محیط کشت آماده ای ام بی (EMB) پلیت ۸ سانتی دو خانه
بسته بندی:
۵ عددی
این محصول در بسته بندی ۵ عددی به فروش می رسد.
محیط کشت EMB (Eosin Methylene Blue) یک محیط کشت انتخابی و افتراقی است که به طور گسترده در میکروبیولوژی، بهویژه برای جداسازی و شناسایی باکتریهای گرم منفی روده (Enterobacteriaceae) استفاده میشود. این محیط به باکتریشناسان کمک میکند تا باکتریهای بیماریزا مانند اشریشیا کلی و سالمونلا را از سایر باکتریهای موجود در نمونههای بالینی و غذایی تشخیص دهند.
ترکیبات اصلی EMB:
پپتون: منبع نیتروژن، کربن، و مواد مغذی برای رشد باکتریها.
لاکتوز: یک قند قابل تخمیر که به عنوان سوبسترا برای شناسایی باکتریهای تخمیرکننده لاکتوز استفاده میشود.
سوکروز (در برخی فرمولاسیونها): قند دیگری که به محیط اضافه میشود تا به شناسایی باکتریهایی که لاکتوز را به کندی تخمیر میکنند کمک کند.
ائوزین Y و متیلن بلو: این دو رنگ، ترکیبات انتخابی و افتراقی محیط هستند